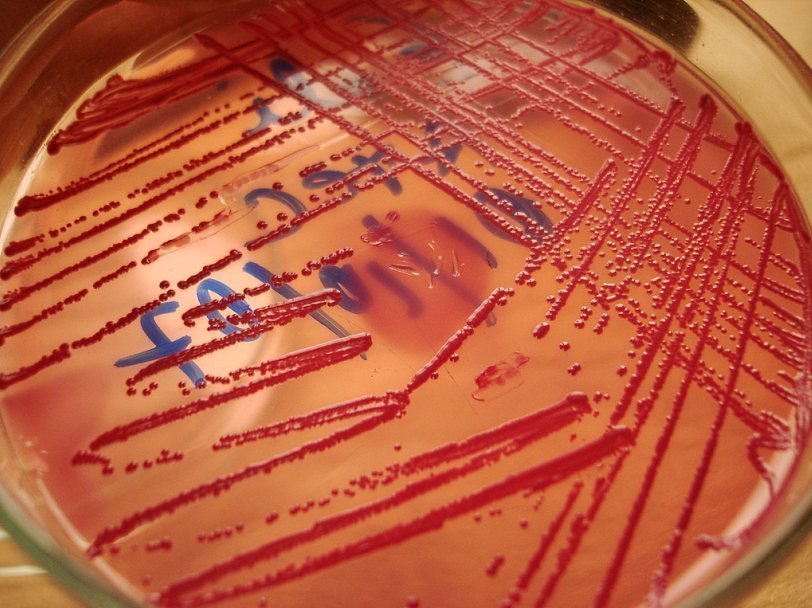

Александра Брутер: Меню выбирает бактерия
Колонии E. coli в чашке Петри Carlos Rosas/Flickr
Колонии E. coli в чашке Петри Carlos Rosas/Flickr Бактерии, живущие в желудочно-кишечном тракте, могут оказывать влияние на пищевое поведение хозяина. Такую гипотезу на основании обзора большого числа независимых исследований выдвинули американские ученые в своей статье в журнале BioEssays.
Случаи, когда паразиты влияют на поведение хозяев, изменяя его в выгодную для них сторону, известны науке. Например, токсоплазма, размножаясь в промежуточном хозяине - крысах, делает так, что крысы больше не испытывают страха при запахе кошачьей мочи и становятся легкой добычей для кошек. Кошки – основные хозяева токсоплазм, только в их организме паразит способен к половому размножению. Поэтому токсоплазма не очень заботится о продолжительности жизни зараженной крысы – ей гораздо выгоднее поскорее попасть в кошку. Более того, запах кошачьей мочи вызывает у крыс сексуальное возбуждение, в результате возрастает вероятность рождения уже зараженных крысят. Чаще всего, правда, паразиты заинтересованы в том, чтобы их хозяин не умер слишком быстро, и могут давать ему преимущества. Описан случай паразитического рачка, который заставляет рыбу поворачивать всегда в одну и ту же сторону. То есть рыба не размышляет, а сразу поворачивает. Это дает ей определенное преимущество при необходимости удрать от хищника, а рачку – возможность подольше не думать о поисках новых хозяев. Но надо понимать, что поведение рачка ни разу не является альтруистическим, просто их с рыбой цели в этот раз совпадают.
Кишечная микрофлора – это, конечно, никакие не паразиты, а симбионты. Но и у них могут быть свои интересы. В частности, они конкурируют между собой. Кишечная микрофлора человека разнообразна и состоит из разных видов бактерий (набор этих видов индивидуален для разных людей, равно как и соотношение численности представителей разных видов). Разные виды предпочитают разную пищу. Кто-то быстрее растет на углеводородах, кому-то выгоднее жиры, кому-то полисахариды. В организме некоторых японцев, диета которых богата морскими водорослями, были найдены микробы, переваривающие эти водоросли, а в организмах африканских детей, основу питания которых составляет сорго, бактерии переваривающие целлюлозу. Если бы кто-то из бактерий-симбионтов научился говорить хозяину: «Давай, ешь немедленно то, что мне выгодно, а соседу – нет», он бы немедленно получил эволюционное преимущество. В опубликованной работе как раз и приводятся свидетельства в пользу того, что кто-то действительно этому научился.
Есть исследование, где показано, что у людей, которые очень любят шоколад, кишечная микрофлора отличается от микрофлоры людей, равнодушных к шоколаду.
Двойные слепые плацебо-контролируемые клинические испытания показали, что употребление пробиотика Lactobacillus casei приводит к улучшению настроения у людей со сниженным настроением. В похожих экспериментах на животных было показано, что этот эффект опосредован блуждающим нервом – если блуждающий нерв перерезан, эффекта не наблюдается.
Кишечные колики у младенцев связаны с характерными особенностями кишечной микрофлоры. Они вызывают у детей дискомфорт, заставляя плакать, что приводит к повышенному вниманию со стороны родителей и внеплановым попыткам покормить. В некоторых случаях отмечалась связь между коликами и слишком быстрым набором веса. Есть гипотеза, что механизм этого и подобных эффектов заключается в продукции бактериями токсинов, которые связываются с болевыми рецепторами на внутренней поверхности желудочно-кишечного тракта. Токсины вырабатываются только тогда, когда нужной еды не поступает. Было также показано, что голод заметно усиливает восприятие боли через блуждающий нерв.
Также есть данные в пользу того, что состав кишечной микрофлоры может влиять на число и активность пищевых рецепторов на языке, а это уж верный способ повлиять на пищевые предпочтения в нужную сторону. Было отмечено, что после некоторых операций на желудке состав и активность этих рецепторов у человека менялась.
Вероятно, бактерии могут влиять на пищевое поведение хозяина гормонами. Серотонин и дофамин – производные аминкислот триптофана и фенилаланина – синтезируются бактериями желудочно-кишечного тракта в количестве чуть ли не большем, чем в нейронах. Различные виды симбионтов синтезируют множество молекул, похожих на сигнальные молекулы организма, связанные с чувством голода: лептин, грелин и т.п. Правда, у организма есть методы борьбы с чужеродными сигнальными молекулами – антитела и разрушающие их ферменты, но это может свидетельствовать о том, что борьба за собственные интересы на этом фронте идет давно.
Некоторые данные свидетельствуют в пользу того, что пробиотики способствуют снижению веса. Чем многочисленнее какой-нибудь один вид, тем сильнее его лобби, и тем сильнее он может влиять на организм хозяина, вызывая нездоровый перекос в какую-нибудь одну сторону пищевого поведения. Поэтому ключ к здоровому пищевому поведению – более разнообразная микрофлора с меньшим представительством каждого вида. Древнеримский принцип «разделяй и властвуй» в действии.
Из всего этого следует несколько выводов, которые в будущем можно будет проверить экспериментально. Если они подтвердятся, придется во многом пересмотреть наши взгляды на расстройство пищевого поведения.
Напрашивается, в частности, вывод, что пищевое поведение заразно. Уже есть исследование, показавшее, что у родственников, живущих под одной крышей сходство кишечной микрофлоры выше, чем у живущих раздельно. Интересно было бы оценить сходства и различия в их пищевом поведении. Другое исследование показало, что вероятность растолстеть повышается на 57%, если кто-то из твоих друзей только что растолстел. То есть речь идет об эпидемии ожирения не в переносном, а в самом прямом смысле этого слова. Лишний вес действительно может быть заразен.
Но есть и хорошие новости. Если описанные выше причинно-следственные связи верны, то манипуляции с кишечной микрофлорой должны приводить к нормализации пищевого поведения. Этому есть и подтверждения. Например, у животных фекальная трансплантация от худых особей с нормальным пищевым поведением к толстым с ненормальным приводит к нормализации веса и пищевого поведения у последних. Возможно, на основании этого или каких-то других методов трансплантации кишечной микрофлоры удастся решить проблему эпидемии ожирения.
Смотрите также: Фекальная трансплантация пришла в Россию Максим Руссо Бар, наука, рок-н-ролл Бактерию научили убивать по команде Подробности о взаимоотношениях микроорганизмов, один из которых живет внутри другого, стали известны биологам